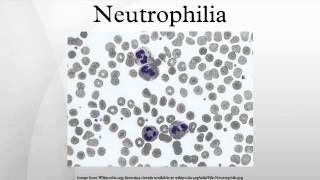

- Medical Coding Training — Difference Between Septicemia, SIRS and Sepsis

\"From the August 2014 Coding Certification Q and A Webinar\": Free for all! Get CEU\'s!\" Medical Coding Training — Difference Between Septicemia, SIRS and ... Watch Now
Watch Now
- Neutrophilia
Neutrophilia (or neutrophil leukocytosis) describes a high number of neutrophil granulocytes in blood. This video is targeted to blind users. Attribution: Article text ... Watch Now
Watch Now
- What Is Leukopenia and What Causes It?

Enjoy this short video as Dr. Purser talks on the cause of leukopenia (low white blood cell count) he sees most commonly in patients. We hope this video helps ... Watch Now
Watch Now
- Case: 50 y.o. w/ early satiety, Splenomegaly and a weird-looking cell on peripheral smear!

Right Now! You can get access to all my hand-written hematology video notes (the notes that I use on my videos) on Patreon...There is a direct link through ... Watch Now
Watch Now
- Case: Weight loss, Splenomegaly, Leukocytosis, Thrombocytosis& Hypercellular marrow

Right Now! You can get access to all my hand-written hematology video notes (the notes that I use on my videos) on Patreon...There is a direct link through ... Watch Now
Watch Now
- Surgical, Site, Infections (SSI) Case Studies

This video is for everyone who is collecting or reporting NHSN SSI Surveillance. This course allows the user to accurately apply the NHSN definitions and ... Watch Now
Watch Now
- Central Line-associated Bloodstream Infections (CLABSI) Case Studies

This video is for everyone who is collecting or reporting NHSN CLABSI Surveillance. This course allows the user to accurately apply the NHSN definitions and ... Watch Now
Watch Now
- E17. Shift to left , Shift to right , Leukemoid reaction

 Watch Now
Watch Now
- Small Bowel Obstruction

This is a Learning in 10 voice annotated presentation (VAP) on Small Bowel Obstruction To learn more about Learning in 10 (LIT), please visit learningin10.com. Watch Now
Watch Now
- Leukemoid Reaction (Arabic 2017)

 Watch Now
Watch Now
Monday, June 17, 2019
Leukocytosis Icd 10
Subscribe to:
Post Comments (Atom)
-
ADAN EVA Y EL GORILLA //EL GORILLA MAS MALO DE TODOS../ Walkthrough perdon por el sonido se me paso por screencast pero bn disfruten.. EL J...
-
【Karaoke】Six Trillion Years and Overnight Story【on vocal】 kemu 六兆年と一夜物語 Rokuchounen to Ichiya Monogatari Six Trillion Years and Overnight S...
-
Convict Fishing - Skyway Fishing Pier Catch & Cook! Convict Fishing - Skyway fishing pier catch and cook! In this episode I show you ho...

No comments:
Post a Comment